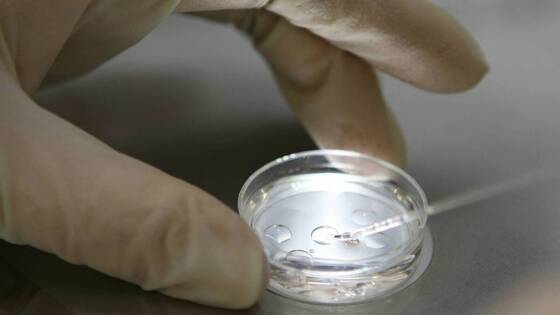

Ученые сообщили об обнаружении вызывающего волчанку вируса
Ученые утверждают, что вирус Эпштейна-Барр (ВЭБ), по-видимому, вызывает волчанку. Связь почти повсеместного распространения ВЭБ с аутоиммунным заболеванием, поражающим примерно 1 из 1000 человек, может стимулировать поиск вакцины.

Согласно новаторским исследованиям, распространенный в детстве вирус, по-видимому, является пусковым механизмом аутоиммунного заболевания волчанка, пишет The Guardian.
Исследование предполагает, что вирус Эпштейна-Барр (ВЭБ), который для большинства людей безвреден, может привести к тому, что иммунные клетки “выйдут из-под контроля” и по ошибке атакуют собственные ткани организма. Команда, стоящая за работой, заявила, что раскрытие причины волчанки может революционизировать методы лечения.
“Мы считаем, что это применимо к 100% случаев волчанки, - сказал профессор Уильям Робинсон, профессор иммунологии и ревматологии Стэнфордского университета и старший автор исследования. – Думаю, что это действительно закладывает основу для нового поколения методов лечения, которые могли бы фундаментально лечить и тем самым приносить пользу пациентам с волчанкой”.
Волчанка, которой страдают около 69 000 человек в одной только Великобритании, является хроническим аутоиммунным заболеванием, при котором иммунная система вырабатывает антитела, которые атакуют собственные ткани организма. Причины этого заболевания до конца не изучены, и нет известного лекарства от него, которое может вызывать боли в суставах и мышцах, сильную усталость и кожную сыпь, поясняет The Guardian.
Эпидемиологические исследования ранее указывали на связь между вирусом Эпштейна-Барр и волчанкой, и эта идея получила широкое распространение после недавнего открытия, доказавшего связь между ВЭБ и рассеянным склерозом, еще одним аутоиммунным заболеванием. Последняя работа помогает раскрыть на клеточном уровне, как ВЭБ, по-видимому, вызывает волчанку, приводя иммунную систему в состояние штопора.
“Это исследование раскрывает тайну, существовавшую десятилетиями”, - комментирует Шейди Юнис, иммунолог из Стэнфорда и первый автор статьи.
Вирус Эпштейна-Барр - это, как правило, легкое заболевание, которое вызывает боль в горле, лихорадку и тонзиллит, указывает The Guardian. К взрослому возрасту около 19 из 20 человек заражаются и, поскольку вирус откладывает свой генетический материал в ДНК, переносят спящий вирус в своих клетках.
“Причина, по которой это так удивительно, заключается в том, что это распространенный вирус, которым большинство из нас заражается от своего брата или сестры за кухонным столом, когда мы растем, а если и нет, то когда мы целуемся с кем-то еще в подростковом возрасте, - отмечает профессор Робинсон. – Практически единственный способ не заболеть ВЭБ - это жить в пузыре”.
К числу типов клеток, в которых постоянно обитает ВЭБ, относятся В-клетки, составляющие часть иммунной системы. Эти клетки специализируются на связывании с белками на поверхности вирусов, известными как антигены. Около 20% В-клеток также обладают потенциалом связываться с частями собственных клеток организма, но у здоровых людей эти “аутореактивные” В-клетки в основном остаются неактивными.
Ученые впервые использовали высокоточное генетическое секвенирование, чтобы выявить различия в количестве и типе В-клеток, инфицированных у 11 пациентов с волчанкой, по сравнению с 10 здоровыми контрольными группами.
В контрольной группе менее 1 из 10 000 В–клеток содержали ВЭБ, по сравнению с примерно 1 из 400 клеток в группе больных волчанкой - разница в 25 раз. ВЭБ также чаще обнаруживался в аутореактивных В-клетках.
Присутствие спящего вируса, по-видимому, переводит эти клетки в гиперактивное состояние, в котором они не только нацеливаются на антигены внутри организма, но и привлекают другие иммунные клетки, включая Т-клетки-киллеры, для участия в атаке.
“Мы считаем, что это важнейшее открытие: ВЭБ... затем активирует эти В-клетки, вызывая аутоиммунный ответ, который вызывает волчанку”, - отмечает Робинсон.
Существуют и другие хорошо известные факторы риска, которые влияют на восприимчивость человека, помимо ВЭБ. Например, волчанка непропорционально часто поражает женщин, что может быть связано с гормонами, такими как эстроген, которые усиливают активность В-клеток, говорит Робинсон. Люди с африканским, карибским или азиатским происхождением также подвержены более высокому риску
Профессор медицины Университета Сорбонны Гай Горохов назвал результаты исследования “впечатляющими”. “Это не последняя статья о волчанке, но они многое сделали и разработали интересную концепцию”, - сказал он.
Если результаты подтвердятся, это придаст импульс клиническим испытаниям вакцины против ВЭБ, которые уже проводятся. Кроме того, несколько команд изучают возможность применения новых методов лечения рака, направленных на уничтожение В-клеток в тяжелых случаях волчанки. Результаты опубликованы в журнале Science Translational Medicine.